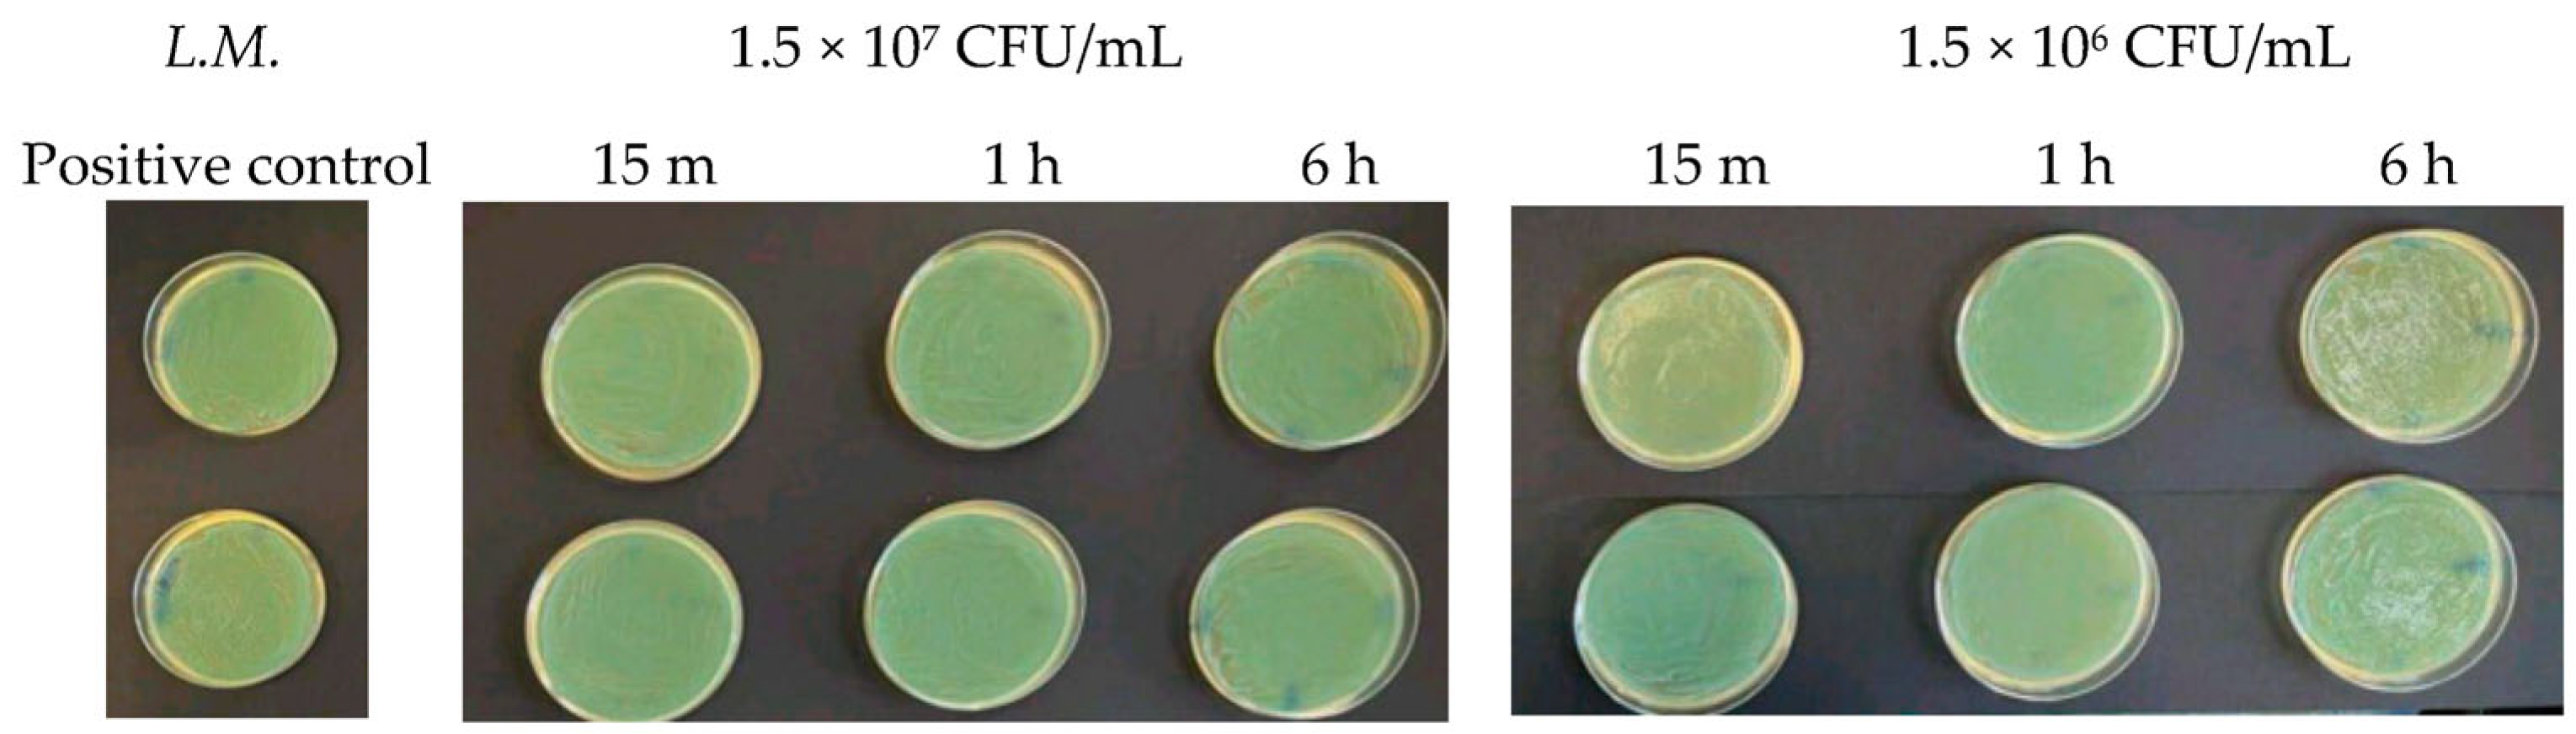
Antibiotics 13 00109 g001 Antibiotics 13 00109 g001
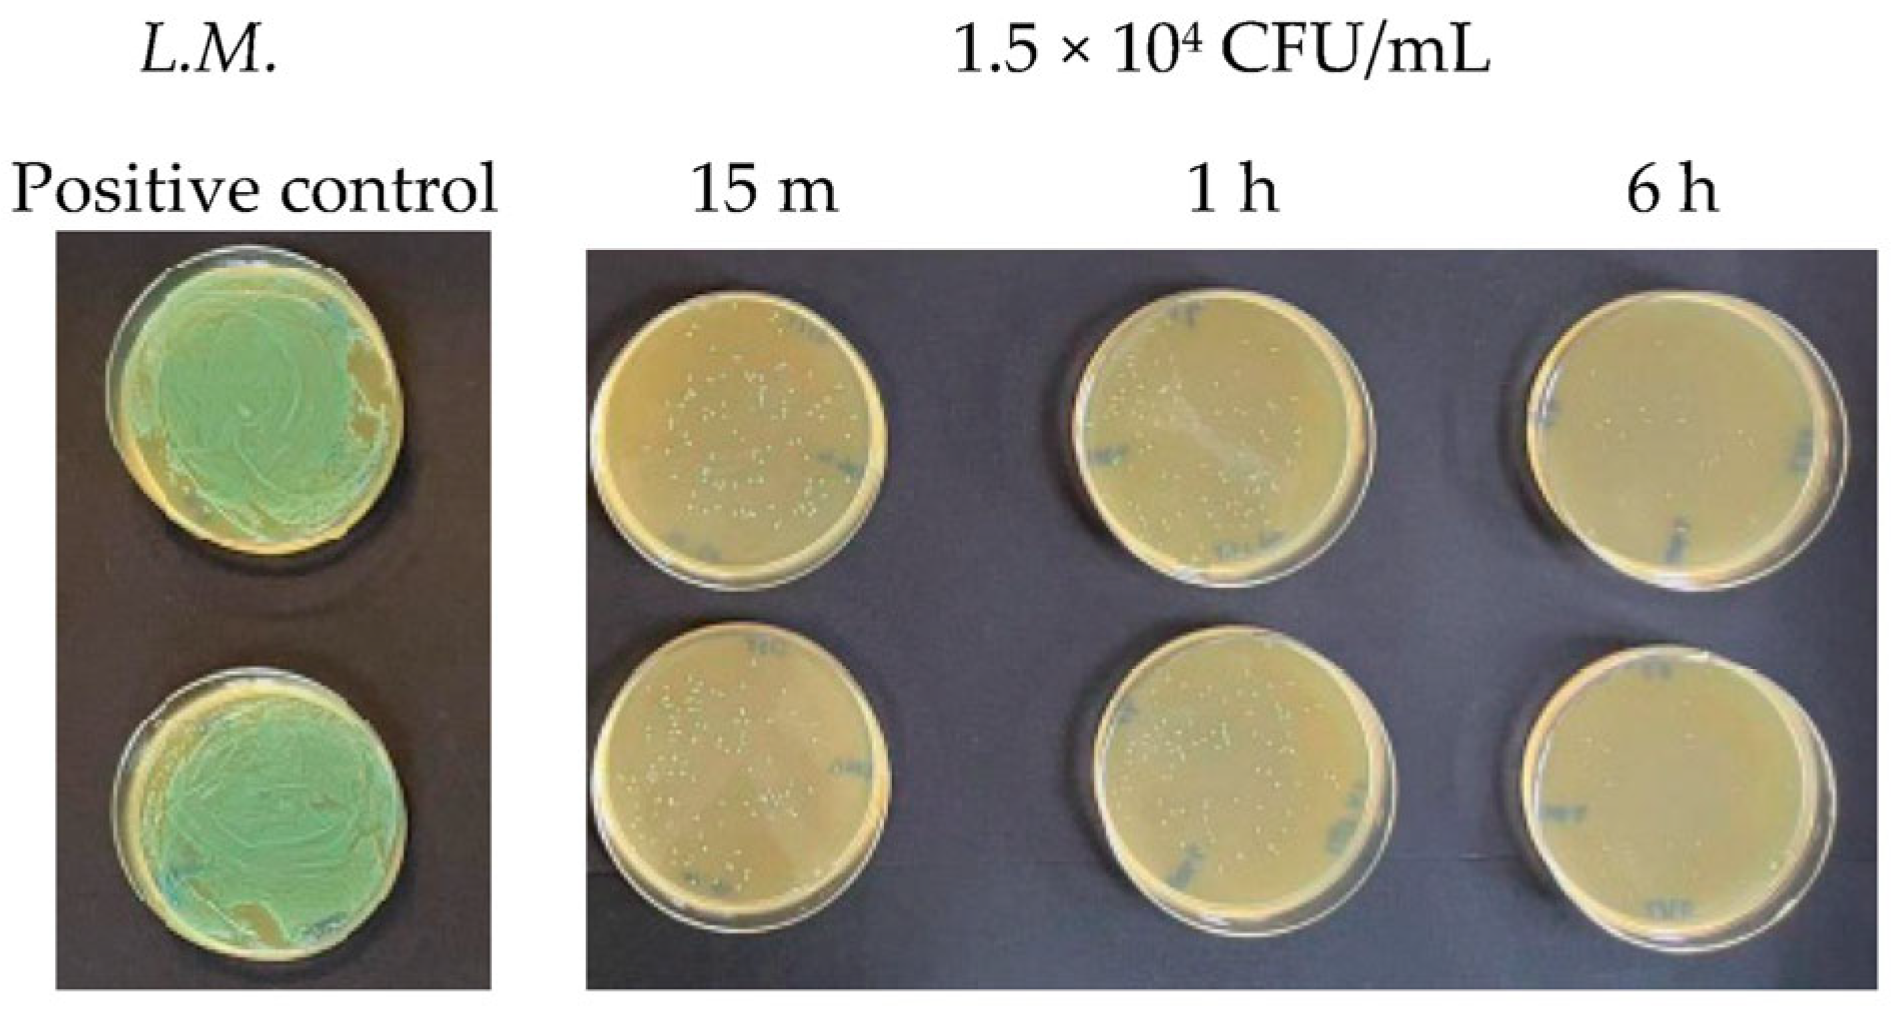
Antibiotics 13 00109 g003 Antibiotics 13 00109 g003
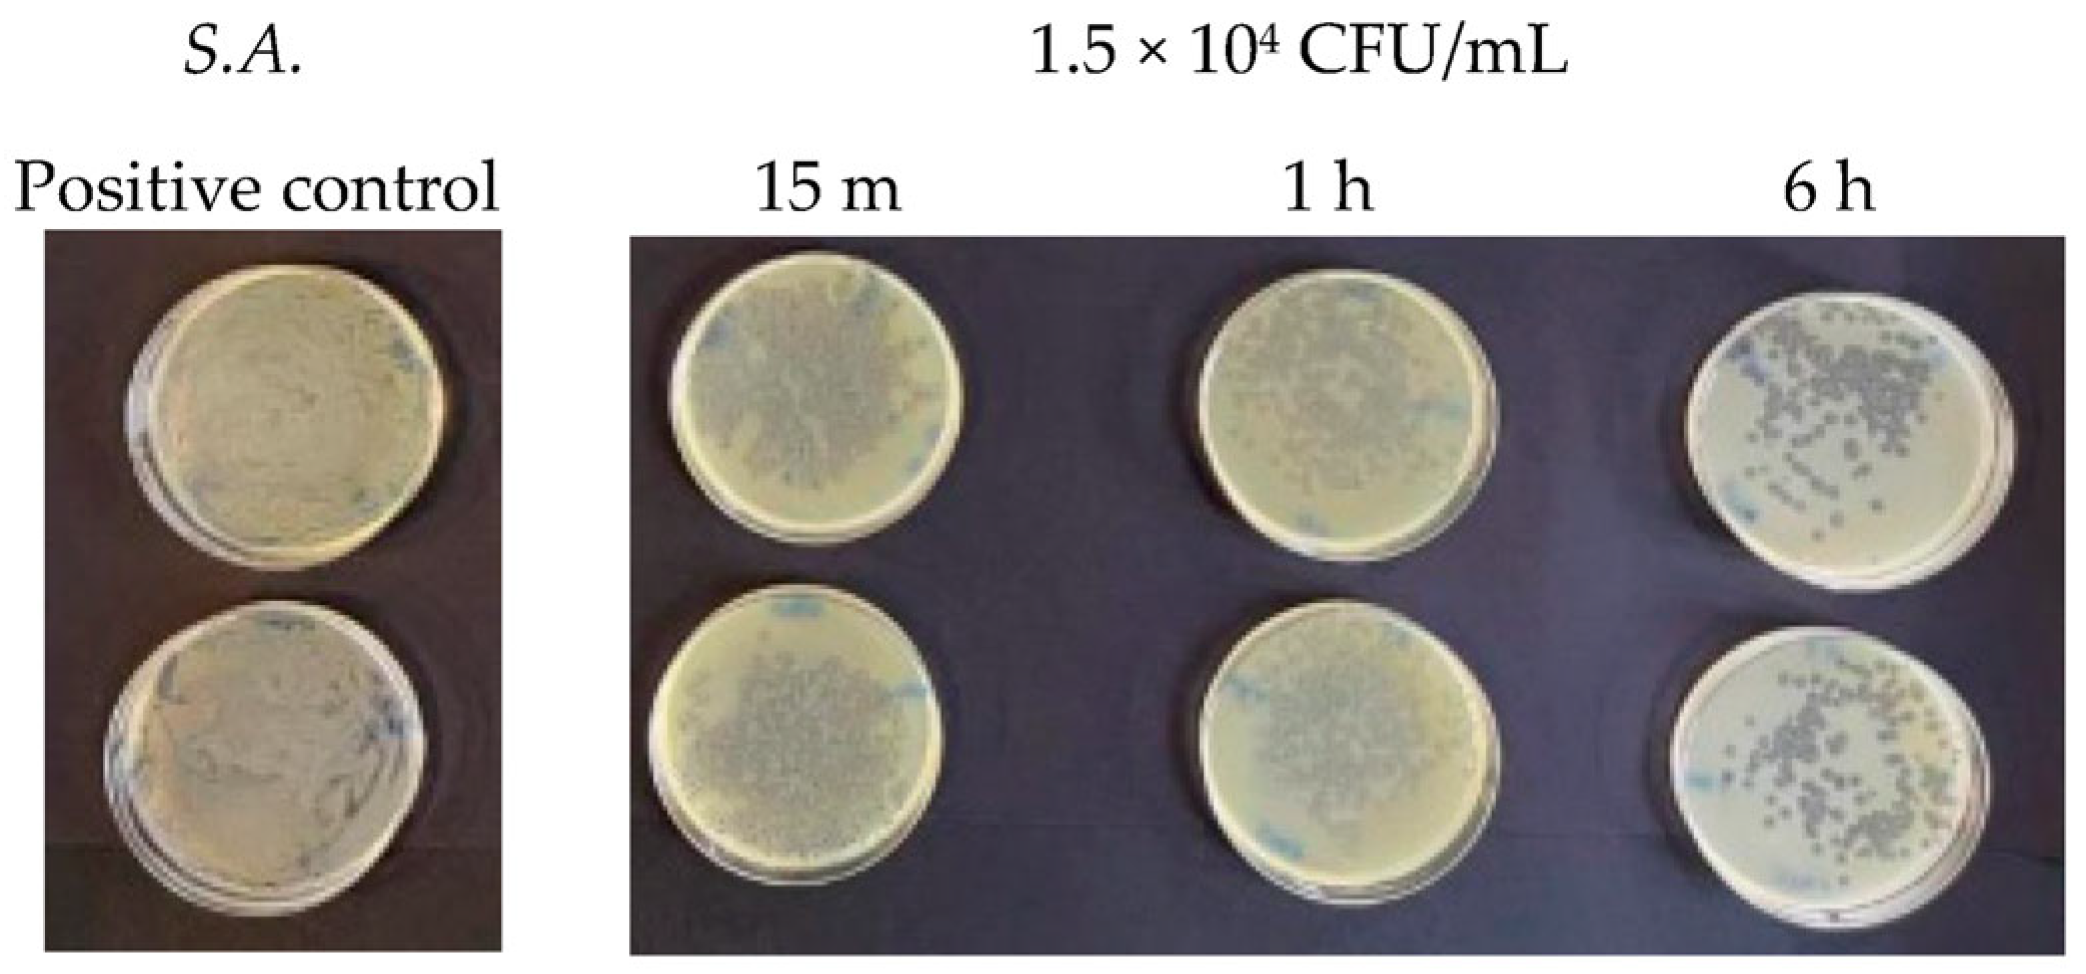
Antibiotics 13 00109 g004 Antibiotics 13 00109 g004
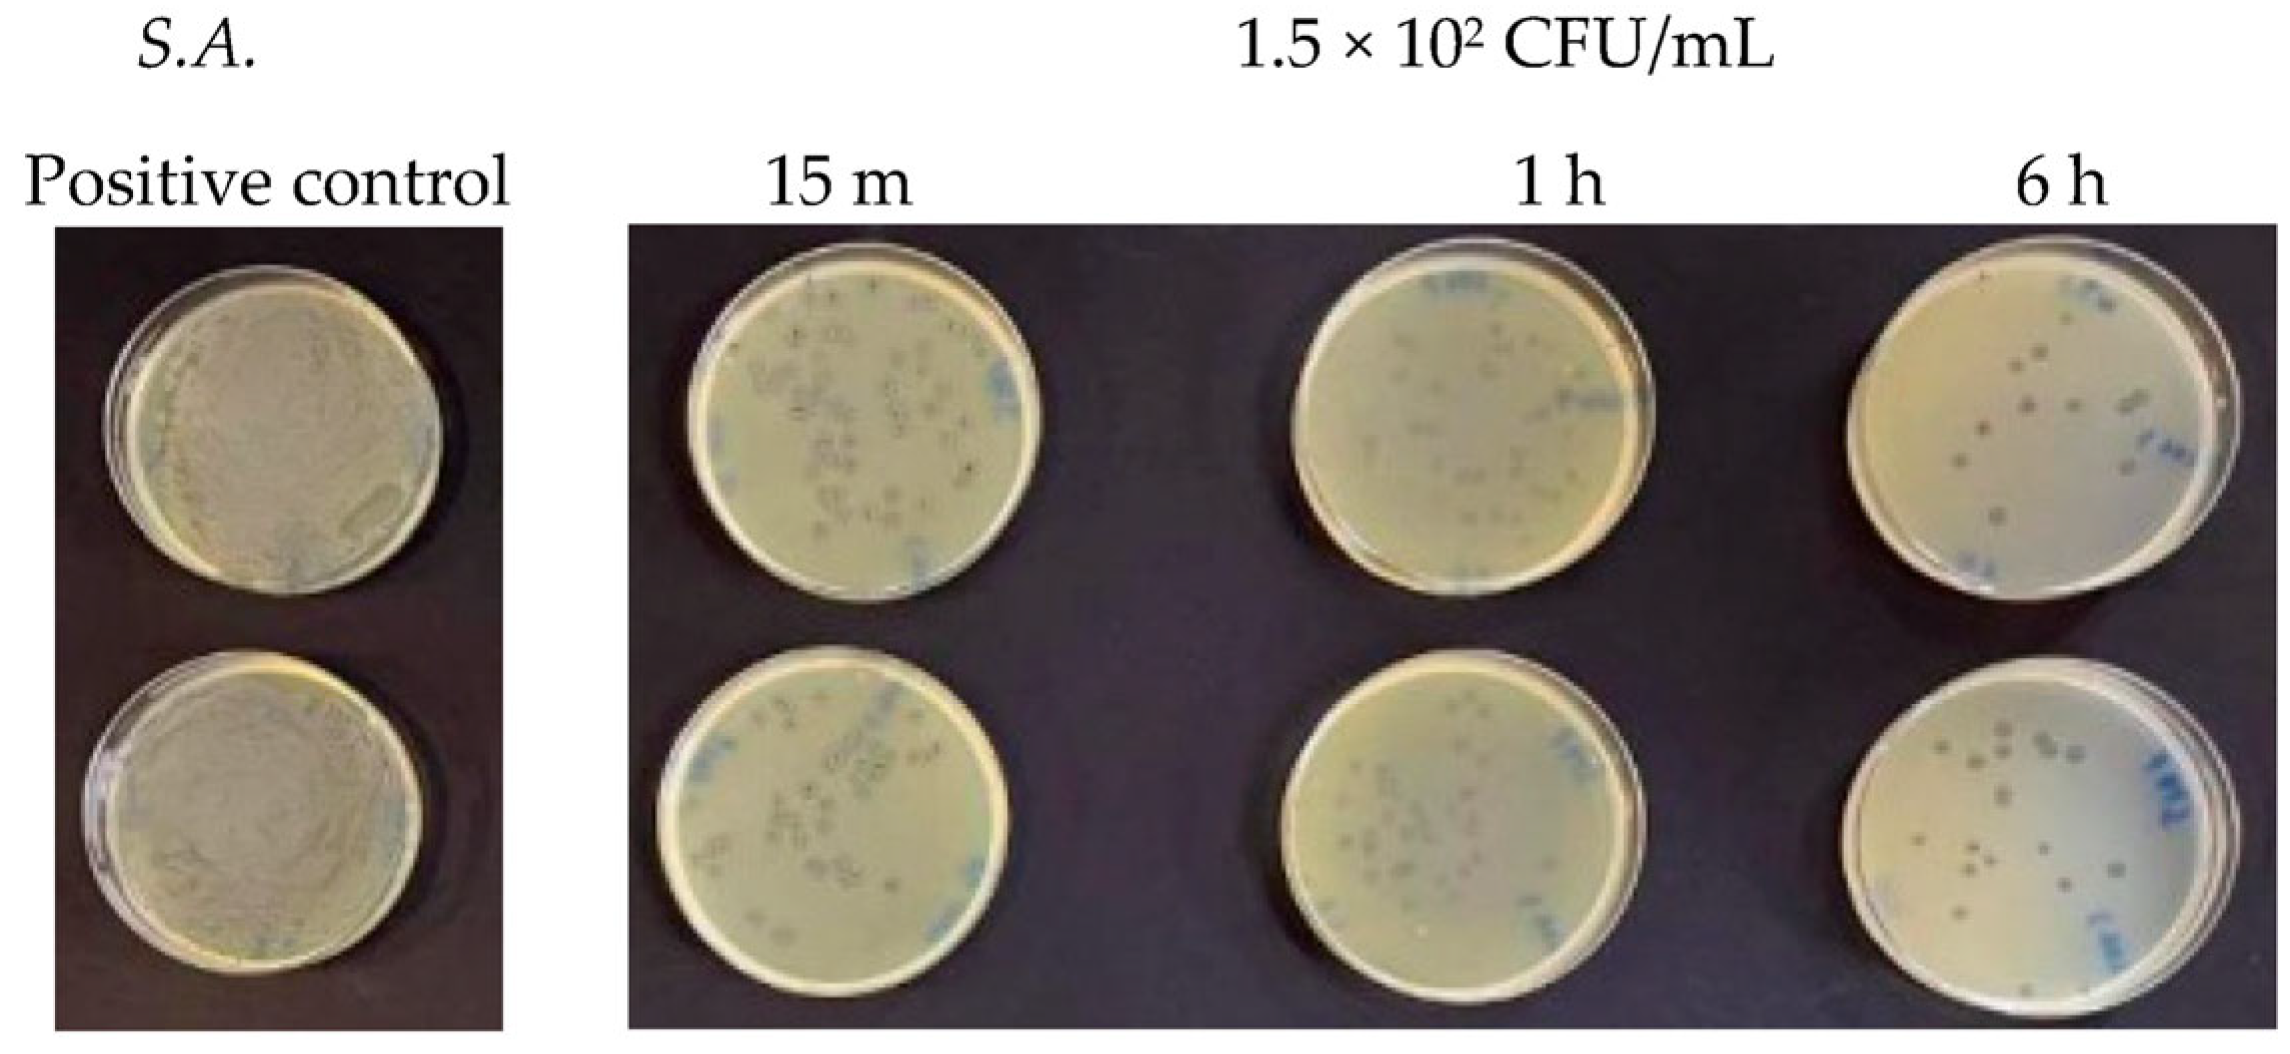
Antibiotics 13 00109 g005 Antibiotics 13 00109 g005
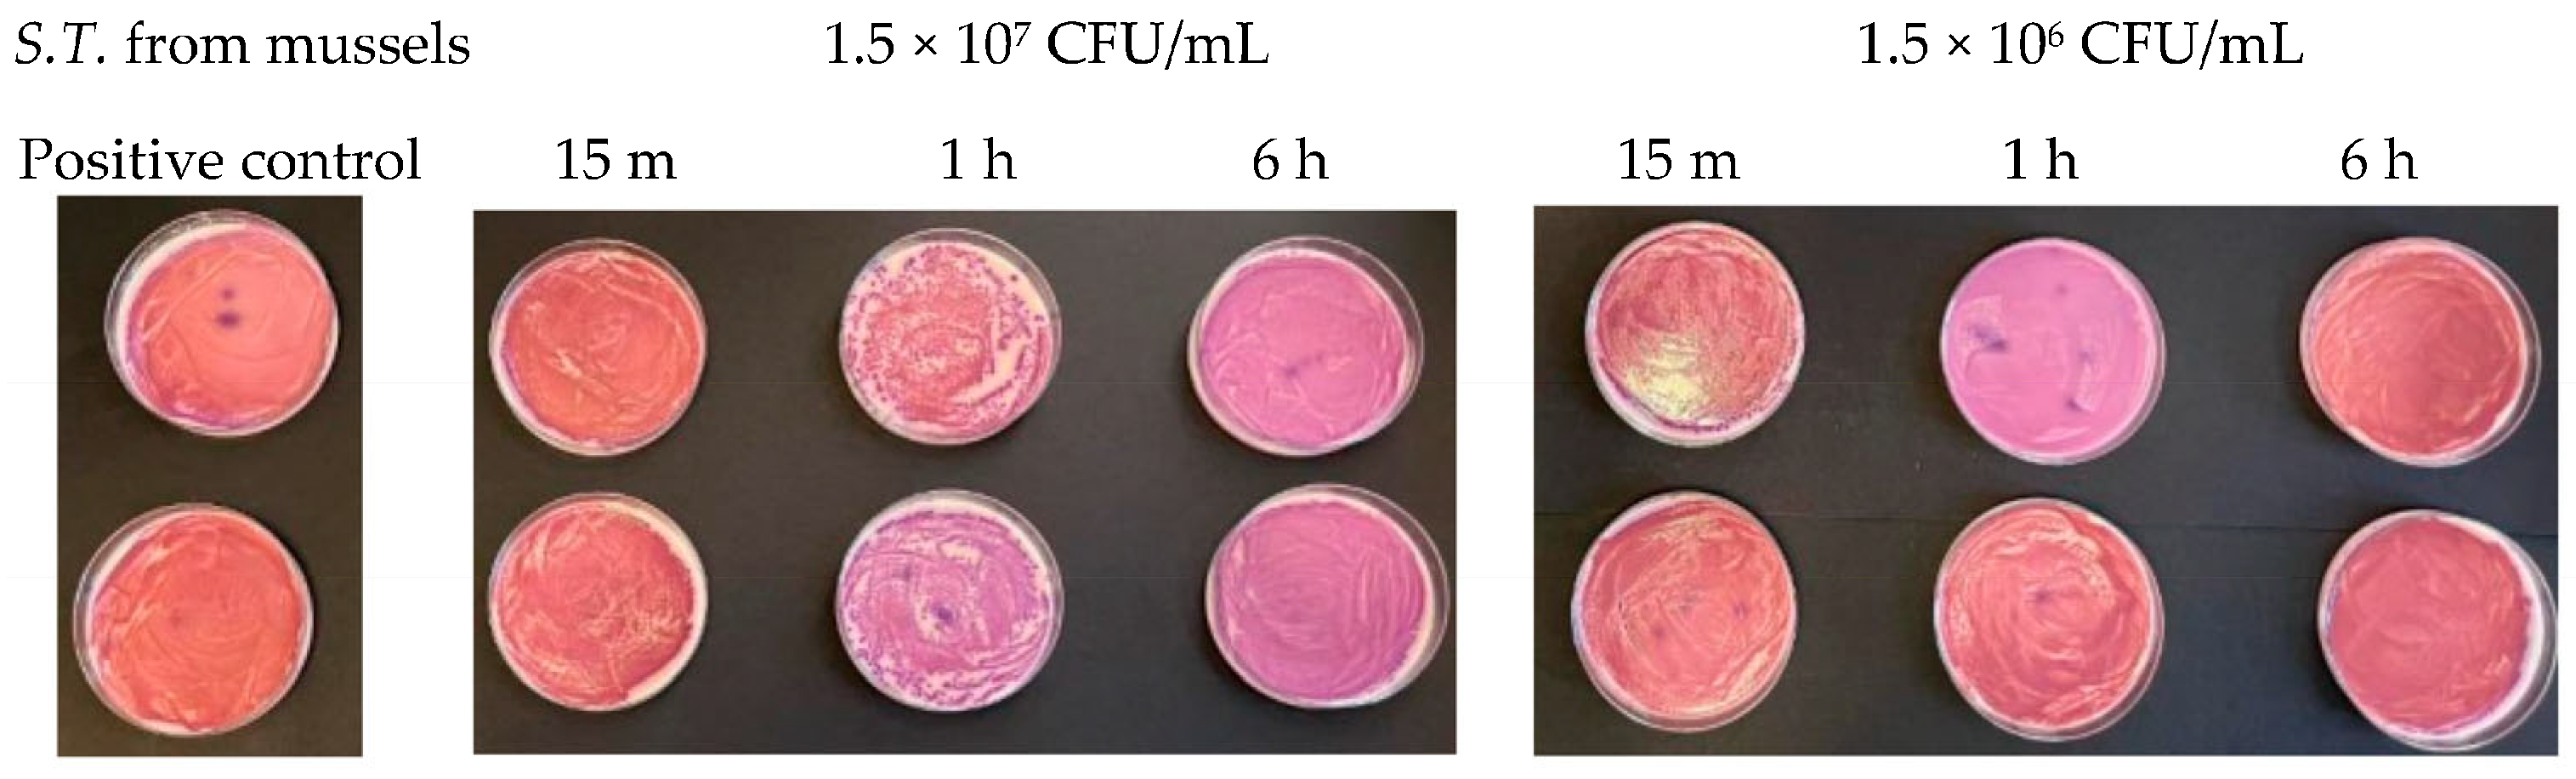
Antibiotics 13 00109 g008 Antibiotics 13 00109 g008
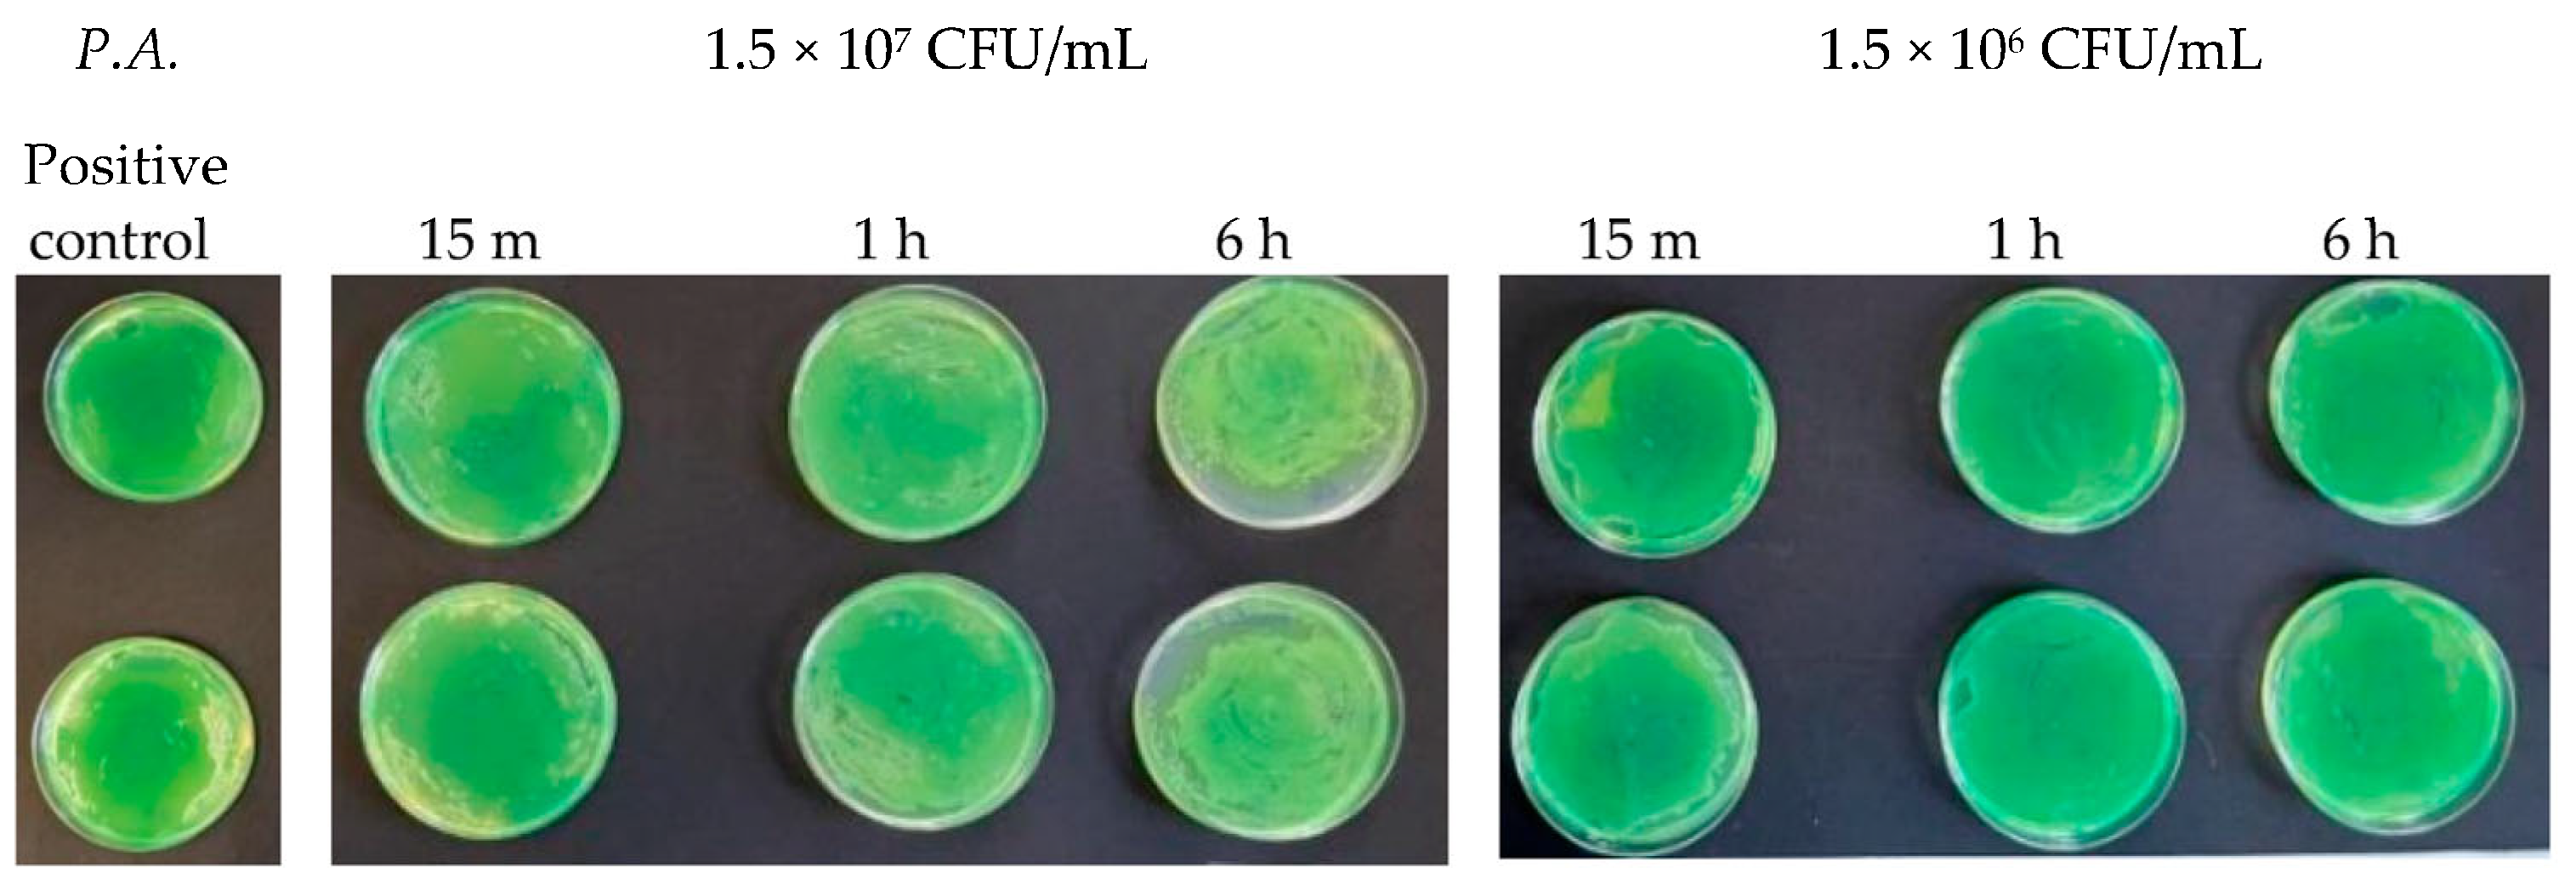
Antibiotics 13 00109 g011 Antibiotics 13 00109 g011

The In Vitro Antibacterial Activity of Argirium SUNc against Most Common Pathogenic and Spoilage Food Bacteria
Abstract
1. Introduction
Silver Nanoparticles
- The top-down method, which is a physical method that involves the breakdown of a bulk material into smaller parts through simple grinding. It is easily applicable, economical, and does not require the use of volatile and toxic compounds. However, the quality of the nanoparticles produced by this method is lower than that of nanocomposites made with the modern bottom-up method, as there might be contamination problems related to milling equipment, irregular shape and size, and high demands [15];
- The bottom-up method, which is a chemical method that involves the use of atomic or molecular raw materials that must be chemically converted into larger nanoparticles. It is expensive, but much more controllable and accurate than the top-down method and, for this reason. the nanoparticles produced using the bottom-up technique, chemically based and designed, are qualitatively better.
- The in situ method, where the monomer is polymerized and the metal ions, which are reduced in the polymer matrix to form nanoparticles, may be introduced before or after polymerization;
- The ex situ method, in which nanoparticles are first synthesized and then introduced into a polymeric solution or a monomer that is subsequently polymerized.
- The nanoparticle is able to attack and break the cell membrane, altering its permeability. Following this penetration, it can also damage the internal cellular compartments, affecting vital functions because it acts on the respiratory chain, blocking bacterial respiration and ATP synthesis, so as to inhibit cell division and cause the death of the cell itself. Furthermore, AgNPs induce the production of reactive oxygen species (ROS), which lead to cellular oxidative stress and apoptosis [26];
- Instead, Ag+ ions have the ability to easily bind to the amino (-NH2), imidazole (CH2)2N(NH)CH, carbonyl (C=O), phosphate R-OPO(OH)2, and thiol groups (R-SH), altering common biological functionalities. They are also able to form complexes with peptides and nucleic acids (DNA or RNA), inhibiting their transcription [27] and interfering with the cell replication process [28].
2. Results
2.1. Determination of Argirium SUNc® Antibacterial Effect against Listeria monocytogenes and Staphylococcus aureus
2.2. Determination of Argirium SUNc® Antibacterial Effect against Pseudomonas aeruginosa, Escherichia coli, Salmonella typhimurium Isolated from Mussels, and Salmonella typhimurium Isolated from Humans
3. Discussion
4. Materials and Methods
4.1. Inoculum Preparation
4.2. Laboratory Tests
- 1.5 × 107 CFU/mL, made up of 10 µL of Argirium SUNc® at a concentration of 22 ppm, 10 µL of the standard inoculum (1.5 × 108 CFU/mL), and 80 µL of Buffered Peptone Water (BPW);
- 1.5 × 106 CFU/mL, made up of 10 µL of Argirium SUNc® at a concentration of 22 ppm, 10 µL of previous inoculum (1.5 × 107 CFU/mL), and 80 µL of Buffered Peptone Water (BPW)
- 1.5 × 104 CFU/mL, made up of 10 µL of Argirium SUNc® at a concentration of 22 ppm, 10 µL of the inoculum at a concentration of 1.5 × 105 CFU/mL, and 80 µL of Buffered Peptone Water (BPW)
- 1.5 × 102 CFU/mL, made up of 10 µL of Argirium SUNc® at a concentration of 22 ppm, 10 µL of the inoculum at a concentration of 1.5 × 103 CFU/mL, and 80 µL of Buffered Peptone Water (BPW);
5. Conclusions
6. Patents
Author Contributions
Funding
Institutional Review Board Statement
Informed Consent Statement
Data Availability Statement
Conflicts of Interest
References
- Su, Z.; Du, T.; Liang, X.; Wang, X.; Zhao, L.; Sun, J.; Wang, J.; Zhang, W. Nanozymes for foodborne microbial contaminants detection: Mechanisms, recent advances, and challenges. Food Control 2022, 141, 109165. [Google Scholar] [CrossRef]
- European Food Safety Authority; European Centre for Disease Prevention and Control. The European Union one health 2019 zoonoses report. EFSA J. 2021, 19, e06406. [Google Scholar]
- World Health Organization. WHO | World Health Organization. Available online: https://www.who.int/ (accessed on 15 August 2021).
- Alekshun, M.N.; Levy, S.B. Molecular Mechanisms of Antibacterial Multidrug Resistance. Cell 2007, 128, 1037–1050. [Google Scholar] [CrossRef] [PubMed]
- Høiby, N.; Ciofu, O.; Johansen, H.K.; Song, Z.J.; Moser, C.; Jensen, P.Ø.; Molin, S.; Givskov, M.; Tolker-Nielsen, T.; Bjarnsholt, T. The Clinical Impact of Bacterial Biofilms. Proc. Int. J. Oral Sci. 2011, 3, 55–65. [Google Scholar] [CrossRef] [PubMed]
- Khan, S.N.; Khan, A.U. Breaking the Spell: Combating Multidrug Resistant “Superbugs”. Front. Microbiol. 2016, 7, 174. [Google Scholar] [CrossRef] [PubMed]
- Qayyum, S.; Khan, A.U. Nanoparticles vs. biofilms: A battle against another paradigm of antibiotic resistance. MedChemComm 2016, 7, 1479–1498. [Google Scholar] [CrossRef]
- ISS. Available online: https://www.epicentro.iss.it (accessed on 21 November 2023).
- Hetta, H.F.; Ramadan, Y.N.; Al-Harbi, A.I.; Ahmed, E.A.; Battah, B.; Abd Ellah, N.H.; Zanetti, S.; Donadu, M.G. Nanotechnology as a Promising Approach to Combat Multidrug Resistant Bacteria: A Comprehensive Review and Future Perspectives. Biomedicines 2023, 11, 413. [Google Scholar] [CrossRef]
- Algammal, A.M.; Hashem, M.E.A.; Alfifi, K.J.; Al-Otaibi, A.S.; Alatawy, M.; ElTarabili, R.M.; El-Ghany, W.A.A.; Hetta, H.F.; Hamouda, A.M.; A Elewa, A.; et al. Sequence Analysis, Antibiogram Profile, Virulence and Antibiotic Resistance Genes of XDR and MDR Gallibacterium anatis Isolated from Layer Chickens in Egypt. Infect. Drug Resist. 2022, 15, 4321–4334. [Google Scholar] [CrossRef]
- Meshaal, A.K.; Hetta, H.F.; Yahia, R.; Abualnaja, K.M.; Mansour, A.T.; Al-Kadmy, I.M.S.; Alghamdi, S.; Dablool, A.S.; Bin Emran, T.; Sedky, H.; et al. In Vitro Antimicrobial Activity of Medicinal Plant Extracts against Some Bacterial Pathogens Isolated from Raw and Processed Meat. Life 2021, 11, 1178. [Google Scholar] [CrossRef]
- Horikoshi, S.; Serpone, N. Microwaves in Nanoparticle Synthesis: Fundamentals and Applications; John Wiley & Sons: Hoboken, NJ, USA, 2013; ISBN 3527648143. [Google Scholar]
- Moses, V. Biological Synthesis of Copper Nanoparticles and Its Impact—A Review. Int. J. Pharm. Sci. Invent. 2014, 3, 6–28. [Google Scholar]
- Rai, M.; Ingle, A.P.; Pandit, R.; Paralikar, P.; Gupta, I.; Chaud, M.V.; dos Santos, C.A. Broadening the spectrum of small-molecule antibacterials by metallic nanoparticles to overcome microbial resistance. Int. J. Pharm. 2017, 532, 139–148. [Google Scholar] [CrossRef] [PubMed]
- Wong, B. The Preparation of Nanocomposite Materials Using Supercritical Carbon Dioxide. Ph.D. Thesis, University of Nottingham, Nottingham, UK, 2005. [Google Scholar]
- Stepanov, A.L. Metal-Polymer Nanocomposites; Nicolais, L., Carotenuto, G., Eds.; John Wiley & Sons: Hoboken, NJ, USA, 2004; pp. 241–263. [Google Scholar]
- Möhler, J.S.; Sim, W.; Blaskovich, M.A.; Cooper, M.A.; Ziora, Z.M. Silver bullets: A new lustre on an old antimicrobial agent. Biotechnol. Adv. 2018, 36, 1391–1411. [Google Scholar] [CrossRef] [PubMed]
- Chernousova, S.; Epple, M. Silver as Antibacterial Agent: Ion, Nanoparticle, and Metal. Angew. Chem. Int. Ed. 2013, 52, 1636–1653. [Google Scholar] [CrossRef] [PubMed]
- Vimbela, G.V.; Ngo, S.M.; Fraze, C.; Yang, L.; Stout, D.A. Antibacterial Properties and Toxicity from Metallic Nanomaterials. Int. J. Nanomed. 2017, 12, 3941–3965. [Google Scholar] [CrossRef] [PubMed]
- Barillo, D.J.; Marx, D.E. Silver in medicine: A brief history BC 335 to present. Burn 2014, 40, S3–S8. [Google Scholar] [CrossRef] [PubMed]
- Liao, C.; Li, Y.; Tjong, S.C. Bactericidal and Cytotoxic Properties of Silver Nanoparticles. Int. J. Mol. Sci. 2019, 20, 449. [Google Scholar] [CrossRef] [PubMed]
- Elechiguerra, J.L.; Burt, J.L.; Morones, J.R.; Camacho-Bragado, A.; Gao, X.; Lara, H.H.; Yacaman, M.J. Interaction of silver nanoparticles with HIV-1. J. Nanobiotechnol. 2005, 3, 6. [Google Scholar] [CrossRef]
- Kim, J.S.; Kuk, E.; Yu, K.N.; Kim, J.-H.; Park, S.J.; Lee, H.J.; Kim, S.H.; Park, Y.K.; Park, Y.H.; Hwang, C.-Y.; et al. Antimicrobial effects of silver nanoparticles. Nanomed. Nanotechnol. Boil. Med. 2007, 3, 95–101, Erratum in Nanomed. Nanotechnol. Biol. Med. 2014, 10, e1119. [Google Scholar] [CrossRef]
- Bhatt, D.; Kavitha, M.; Nisha, C.K.; Mahajan, Y. Nanotechnology Solutions to Combat Superbugs. 2013. Available online: https://www.nanowerk.com/spotlight/spotid=32188.php (accessed on 21 November 2023).
- Franci, G.; Falanga, A.; Galdiero, S.; Palomba, L.; Rai, M.; Morelli, G.; Galdiero, M. Silver Nanoparticles as Potential Antibacterial Agents. Molecules 2015, 20, 8856–8874. [Google Scholar] [CrossRef]
- Xu, L.; Wang, Y.-Y.; Huang, J.; Chen, C.-Y.; Wang, Z.-X.; Xie, H. Silver nanoparticles: Synthesis, medical applications and biosafety. Theranostics 2020, 10, 8996–9031. [Google Scholar] [CrossRef]
- Konop, M.; Damps, T.; Misicka, A.; Rudnicka, L. Certain Aspects of Silver and Silver Nanoparticles in Wound Care: A Minireview. J. Nanomater. 2016, 2016, 47. [Google Scholar] [CrossRef]
- Ovington, L.G. The Truth about Silver. Ostomy Wound Manag. 2004, 50, 1S–10S. [Google Scholar]
- Pal, S.; Tak, Y.K.; Song, J.M. Does the Antibacterial Activity of Silver Nanoparticles Depend on the Shape of the Nanoparticle? A Study of the Gram-Negative Bacterium Escherichia coli. Appl. Environ. Microbiol. 2007, 73, 1712–1720. [Google Scholar] [CrossRef] [PubMed]
- Menichetti, A.; Mavridi-Printezi, A.; Mordini, D.; Montalti, M. Effect of Size, Shape and Surface Functionalization on the Antibacterial Activity of Silver Nanoparticles. J. Funct. Biomater. 2023, 14, 244. [Google Scholar] [CrossRef] [PubMed]
- Kooti, M.; Sedeh, A.N.; Motamedi, H.; Rezatofighi, S.E. Magnetic graphene oxide inlaid with silver nanoparticles as antibacterial and drug delivery composite. Appl. Microbiol. Biotechnol. 2018, 102, 3607–3621. [Google Scholar] [CrossRef] [PubMed]
- Mohamed, D.S.; Abd El-Baky, R.M.; Sandle, T.; Mandour, S.A.; Ahmed, E.F. Antimicrobial Activity of Silver-Treated Bacteria against other Multi-Drug Resistant Pathogens in Their Environment. Antibiotics 2020, 9, 181. [Google Scholar] [CrossRef] [PubMed]
- Popova, T.P.; Ignatov, I. In vitro antimicrobial activity of colloidal nano silver. Bulg. J. Vet. Med. 2023, 26, 168–181. [Google Scholar] [CrossRef]
- Dakal, T.C.; Kumar, A.; Majumdar, R.S.; Yadav, V. Mechanistic basis of antimicrobial actions of silver nanoparticles. Front. Microbiol. 2016, 7, 1831. [Google Scholar] [CrossRef]
- Slavin, Y.N.; Asnis, J.; Häfeli, U.O.; Bach, H. Metal nanoparticles: Understanding the mechanisms behind antibacterial activity. J. Nanobiotechnol. 2017, 15, 65. [Google Scholar] [CrossRef]
- Feng, Q.L.; Wu, J.; Chen, G.Q.; Cui, F.Z.; Kim, T.N.; Kim, J.O. A Mechanistic Study of the Antibacterial Effect of Silver Ions on Escherichia coli and Staphylococcus aureus. J. Biomed. Mater. Res. 2000, 52, 662–668. [Google Scholar] [CrossRef]
- Rai, M.K.; Deshmukh, S.D.; Ingle, A.P.; Gade, A.K. Silver nanoparticles: The powerful nanoweapon against multidrug-resistant bacteria. J. Appl. Microbiol. 2012, 112, 841–852. [Google Scholar] [CrossRef] [PubMed]
- Domínguez, A.V.; Algaba, R.A.; Canturri, A.M.; Villodres, R.; Smani, Y. Antibacterial Activity of Colloidal Silver against Gram-Negative and Gram-Positive Bacteria. Antibiotics 2020, 9, 36. [Google Scholar] [CrossRef] [PubMed]
- Hernandez, J.B.M.; Scotti, L.; Valbonetti, L.; Gioia, L.; Paparella, A.; Paludi, D.; Aceto, A.; Ciriolo, M.R.; Lopez, C.C. Effect of membrane depolarization against Aspergillus niger GM31 resistant by ultra nanoclusters characterized by Ag2+ and Ag3+ oxidation state. Sci. Rep. 2023, 13, 2716. [Google Scholar] [CrossRef] [PubMed]
- Molina-Hernandez, J.B.; Aceto, A.; Bucciarelli, T.; Paludi, D.; Valbonetti, L.; Zilli, K.; Scotti, L.; Chaves-López, C. The membrane depolarization and increase intracellular calcium level produced by silver nanoclusters are responsible for bacterial death. Sci. Rep. 2021, 11, 21557. [Google Scholar] [CrossRef] [PubMed]
- Orfei, B.; Moretti, C.L.; Loreti, S.; Tatulli, G.; Onofri, A.; Scotti, L.; Aceto, A.; Buonauro, R. Silver nanoclusters with Ag2+/3+ oxidative states are a new highly effective tool against phytopathogenic bacteria. Appl. Microbiol. Biotechnol. 2023, 107, 4519. [Google Scholar] [CrossRef] [PubMed]
- Sorrentino, S.; Bucciarelli, T.; Corsaro, A.; Tosatto, A.; Thellung, S.; Villa, V.; Schininà, M.E.; Maras, B.; Galeno, R.; Scotti, L.; et al. Calcium Binding Promotes Prion Protein Fragment 90–231 Conformational Change toward a Membrane Destabilizing and Cytotoxic Structure. PLoS ONE 2012, 7, e38314. [Google Scholar] [CrossRef]
- Gasbarri, C.; Ronci, M.; Aceto, A.; Vasani, R.; Iezzi, G.; Florio, T.; Barbieri, F.; Angelini, G.; Scotti, L. Structure and Properties of Electrochemically Synthesized Silver Nanoparticles in Aqueous Solution by High-Resolution Techniques. Molecules 2021, 26, 5155. [Google Scholar] [CrossRef]
- Gasbarri, C.; Ruggieri, F.; Foschi, M.; Aceto, A.; Scotti, L.; Angelini, G. Simple Determination of Silver Nanoparticles Concentration as Ag+ by Using ISE as Potential Alternative to ICP Optical Emission Spectrometry. ChemistrySelect 2019, 4, 9501–9504. [Google Scholar] [CrossRef]

| Listeria monocytogenes | 15 min | 1 h | 6 h |
|---|---|---|---|
| Microbial concentration | 1.5 × 102 CFU/mL | ||
| Plate 1 | 720 CFU/mL | 816 CFU/mL | 448 CFU/mL |
| Plate 2 | 792 CFU/mL | 824 CFU/mL | 1004 CFU/mL |
| Inhibition percentage (%) | 49.6 | 45.3 | 51.6 |
| Microbial concentration | 1.5 × 104 CFU/ml | ||
| Plate 1 | 99 CFU/mL | 98 CFU/mL | 31 CFU/mL |
| Plate 2 | 108 CFU/mL | 89 CFU/mL | 28 CFU/mL |
| Inhibition percentage (%) | 99.3 | 99.4 | 99.8 |
| Staphylococcus aureus | 15 min | 1 h | 6 h |
|---|---|---|---|
| Microbial concentration | 1.5 × 102 CFU/mL | ||
| Plate 1 | 54 CFU/mL | 47 CFU/mL | 14 CFU/mL |
| Plate 2 | 69 CFU/mL | 39 CFU/mL | 21 CFU/mL |
| Inhibition percentage (%) | 95.9 | 97.1 | 98.8 |
| Microbial concentration | 1.5 × 104 CFU/ml | ||
| Plate 1 | 473 CFU/mL | 460 CFU/mL | 221 CFU/mL |
| Plate 2 | 448 CFU/mL | 400 CFU/mL | 201 CFU/mL |
| Inhibition percentage (%) | 96.9 | 97.1 | 98.59 |
| Pseudomonas aeruginosa | 15 min | 1 h | 6 h |
|---|---|---|---|
| Microbial concentration | 1.5 × 102 CFU/mL | ||
| Plate 1 | 1 CFU/mL | 0 CFU/mL | 0 CFU/mL |
| Plate 2 | 0 CFU/mL | 0 CFU/mL | 0 CFU/mL |
| Inhibition percentage (%) | 99.97 | 100 | 100 |
| Microbial concentration | 1.5 × 104 CFU/ml | ||
| Plate 1 | 10 CFU/mL | 0 CFU/mL | 0 CFU/mL |
| Plate 2 | 14 CFU/mL | 0 CFU/mL | 0 CFU/mL |
| Inhibition percentage (%) | 99.9 | 100 | 100 |
| Escherichia coli | 15 min | 1 h | 6 h |
|---|---|---|---|
| Microbial concentration | 1.5 × 102 CFU/mL | ||
| Plate 1 | 1 CFU/mL | 0 CFU/mL | 0 CFU/mL |
| Plate 2 | 0 CFU/mL | 0 CFU/mL | 0 CFU/mL |
| Inhibition percentage (%) | 99.97 | 100 | 100 |
| Microbial concentration | 1.5 × 104 CFU/mL | ||
| Plate 1 | 0 CFU/mL | 0 CFU/mL | 0 CFU/mL |
| Plate 2 | 0 CFU/mL | 0 CFU/mL | 149 CFU/mL |
| Inhibition percentage (%) | 100 | 100 | 99.01 |
| Salmonella typhimurium Isolated from Mussels | 15 min | 1 h | 6 h |
|---|---|---|---|
| Microbial concentration | 1.5 × 102 CFU/mL | ||
| Plate 1 | 6 CFU/mL | 2 CFU/mL | 0 CFU/mL |
| Plate 2 | 3 CFU/mL | 2 CFU/mL | 0 CFU/mL |
| Inhibition percentage (%) | 99.7 | 99.87 | 100 |
| Microbial concentration | 1.5 × 104 CFU/mL | ||
| Plate 1 | 44 CFU/mL | 20 CFU/mL | 0 CFU/mL |
| Plate 2 | 32 CFU/mL | 13 CFU/mL | 1 CFU/mL |
| Inhibition percentage (%) | 99.7 | 98.89 | 99.997 |
| Salmonella typhimurium Isolated from Humans | 15 min | 1 h | 6 h |
|---|---|---|---|
| Microbial concentration | 1.5 × 102 CFU/mL | ||
| Plate 1 | 3 CFU/mL | 3 CFU/mL | 0 CFU/mL |
| Plate 2 | 6 CFU/mL | 5 CFU/mL | 0 CFU/mL |
| Inhibition percentage (%) | 99.7 | 99.7 | 100 |
| Microbial concentration | 1.5 × 104 CFU/mL | ||
| Plate 1 | 73 CFU/mL | 27 CFU/mL | 3 CFU/mL |
| Plate 2 | 70 CFU/mL | 20 CFU/mL | 3 CFU/mL |
| Inhibition percentage (%) | 99.5 | 99.8 | 99.98 |
Disclaimer/Publisher’s Note: The statements, opinions and data contained in all publications are solely those of the individual author(s) and contributor(s) and not of MDPI and/or the editor(s). MDPI and/or the editor(s) disclaim responsibility for any injury to people or property resulting from any ideas, methods, instructions or products referred to in the content. |
© 2024 by the authors. Licensee MDPI, Basel, Switzerland. This article is an open access article distributed under the terms and conditions of the Creative Commons Attribution (CC BY) license (https://creativecommons.org/licenses/by/4.0/).
Share and Cite
Mancusi, A.; Egidio, M.; Marrone, R.; Scotti, L.; Paludi, D.; Dini, I.; Proroga, Y.T.R. The In Vitro Antibacterial Activity of Argirium SUNc against Most Common Pathogenic and Spoilage Food Bacteria. Antibiotics 2024, 13, 109. https://doi.org/10.3390/antibiotics13010109
Mancusi A, Egidio M, Marrone R, Scotti L, Paludi D, Dini I, Proroga YTR. The In Vitro Antibacterial Activity of Argirium SUNc against Most Common Pathogenic and Spoilage Food Bacteria. Antibiotics. 2024; 13(1):109. https://doi.org/10.3390/antibiotics13010109
Chicago/Turabian StyleMancusi, Andrea, Marica Egidio, Raffaele Marrone, Luca Scotti, Domenico Paludi, Irene Dini, and Yolande Thérèse Rose Proroga. 2024. "The In Vitro Antibacterial Activity of Argirium SUNc against Most Common Pathogenic and Spoilage Food Bacteria" Antibiotics 13, no. 1: 109. https://doi.org/10.3390/antibiotics13010109
APA StyleMancusi, A., Egidio, M., Marrone, R., Scotti, L., Paludi, D., Dini, I., & Proroga, Y. T. R. (2024). The In Vitro Antibacterial Activity of Argirium SUNc against Most Common Pathogenic and Spoilage Food Bacteria. Antibiotics, 13(1), 109. https://doi.org/10.3390/antibiotics13010109

